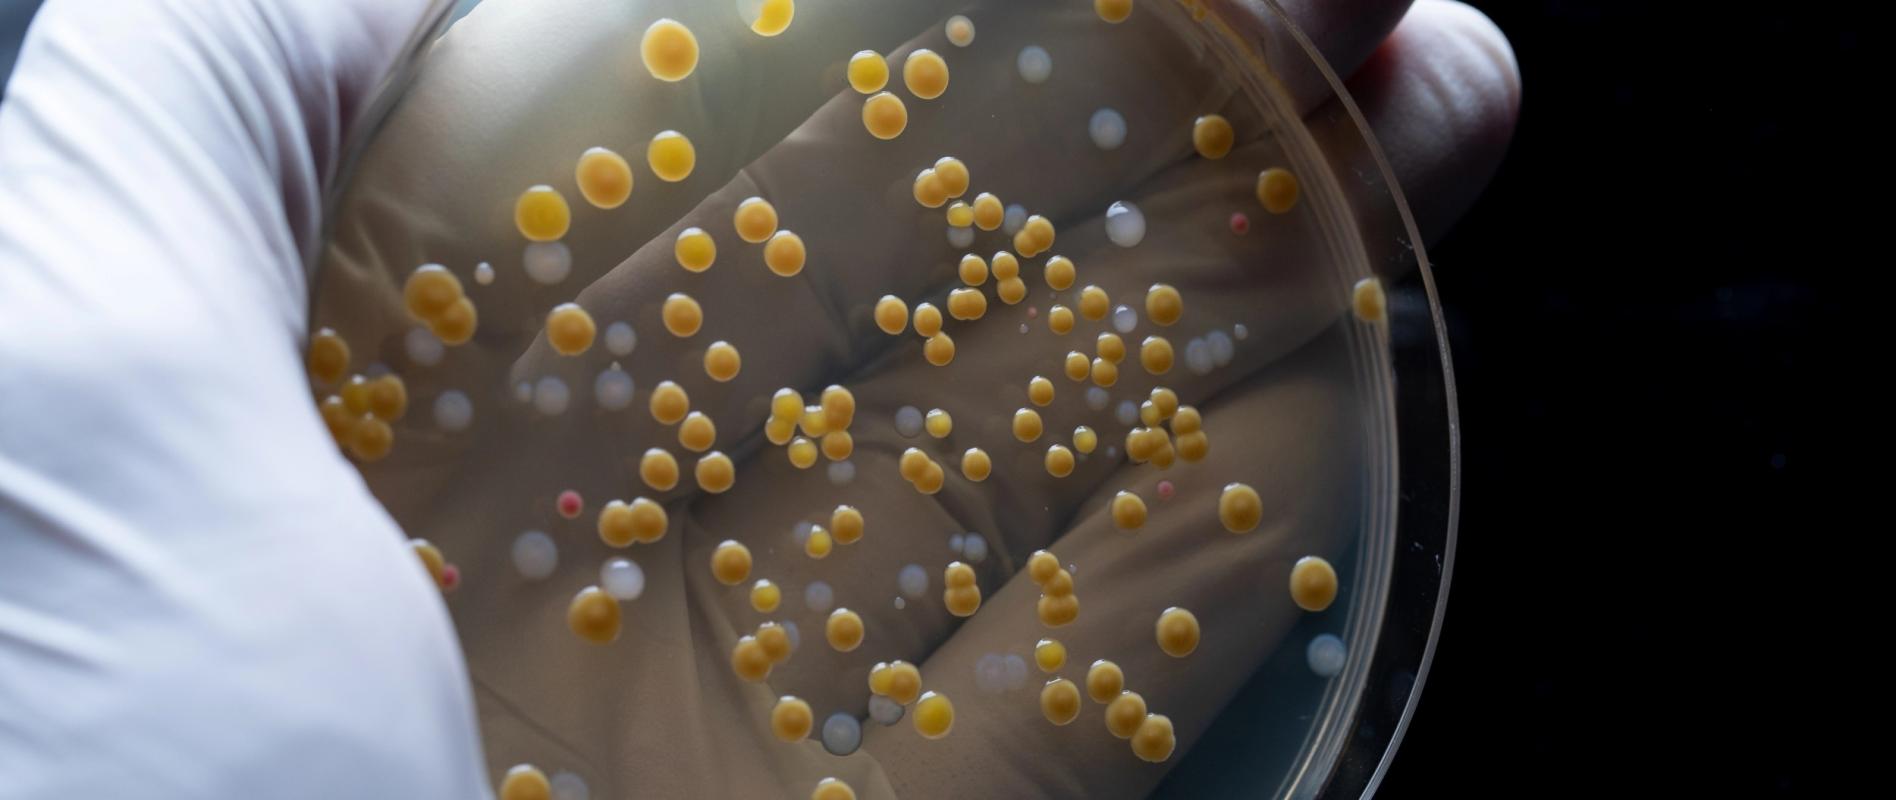
Mikroviologiko - Nitsos Lab

Στο μικροβιολογικό μας εργαστήριο εκτελούνται εξετάσεις και καλλιέργειες βιολογικών υγρών τόσο για προληπτικούς όσο και για λόγους παρακολούθησης ή έγκαιρης ανίχνευσης μικροβίων.
Ενδεικτικά διενεργούνται οι παρακάτω εξετάσεις:
- Καλλιέργεια διαφόρων βιολογικών δειγμάτων ( ούρα, κόπρανα, σπέρμα, κολπικό έκκριμα κ.α )
- Απομόνωση και ταυτοποίηση μικροβίων
- Έλεγχος ευαισθησίας στα αντιοβιοτικά - MIC
- Σπερμοδιάγραμμα - διερεύνηση υπογονιμότητας - DFI (κατακερματισμός DNA)
- Μοριακή μικροβιολογία (PCR - NGS)